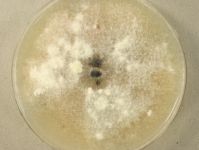
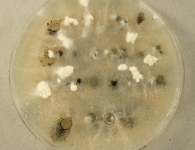

<< back to search
IMAGES:

Search Details
add to cart
| UAMH Number: | 9410 |
|---|---|
| Species Name: | Plenodomus lingam |
| Type: | |
| Synonyms: | Aposphaeria brassicae / Aposphaeria densiuscula / Coniothyrium densiusculum / Depazea brassicae / Depazea brassicicola / Depazea vagans var. brassicae / Heptameria maculans / Heptameria virginica / Leptosphaeria maculans / Leptosphaeria napi / Leptosphaeria virginica / Phoma brassicae / Phoma densiuscula / Phoma lingam / Phoma lingam var. napobrassicae / Phoma napobrassicae / Phyllosticta brassicae / Phyllosticta turritis / Plenodomus rabenhorstii / Pleospora maculans / Pleospora napi / Sclerotium sphaeriaeforme / Sclerotium sphaeriiforme / Septoria brassicae / Sphaeria brassicae / Sphaeria lingam / Sphaeria maculans / Sphaeria napi / Sphaeria virginica / Sphaeropsis lingam |
| Taxonomy: | FUNGI Ascomycota, Dothideomycetes, Pleosporales, Leptosphaeriaceae |
| Strain History: | Khasa, P.D. (3329-60) -> UAMH |
| Substrate: | virulent strain from black leg of Brassica sp. | Location: | UNKNOWN (GEO: ?,?) |
| Isolator: | |
| Isolation Date: | |
| Date Received: | 1998-11-19 |
| Characters: | APPLICATION interactions of the cruciferous phytoalexins with Leptosphaeria maculans - Pedras MS, Sarma-Mamillapalle VK, Bioorg Med Chem20:3991-3996, 2012 // APPLICATION metabolism of dithiocarbamates by Leptosphaeria maculans - Pedras MS, Sarma-Mamillapalle VK, J Agric Food Chem 60:7792-7798, 2012 // APPLICATION molecular interactions of the phytotoxins destruxin B and sirodesmin PL with crucifers and cereals - Pedras MS, Khallaf I, Phytochemistry77:129-139, 2012 // PLANT PATHOGEN blackleg resistance (Brassica napus) - (Click for publications citing UAMH 9410) |
| Compounds: | |
| Cross Reference: | |
| Collections: | Living Strains; Dried Herbarium Material |
| Pathogenic Potential: | Human: no | Animal: no | Plant: yes |
| Biosafety Risk Group: | RG1 (check the PHAC ePATHogen Risk Group Database for updates) |
| Regulatory Requirements: | Canadian requesters must provide PHAC Pathogen and Toxin License Number (see: https://www.canada.ca/en/public-health/services/laboratory-biosafety-biosecurity/licensing-program.html) prior to shipment. International requesters must provide all legally required importation documentation prior to shipment. Plant pathogenicity status may be verified by using the USDA Agricultural Research Service (ARS) Fungal Database |
| MycoBank ID: | 416165 |
IMAGES:
